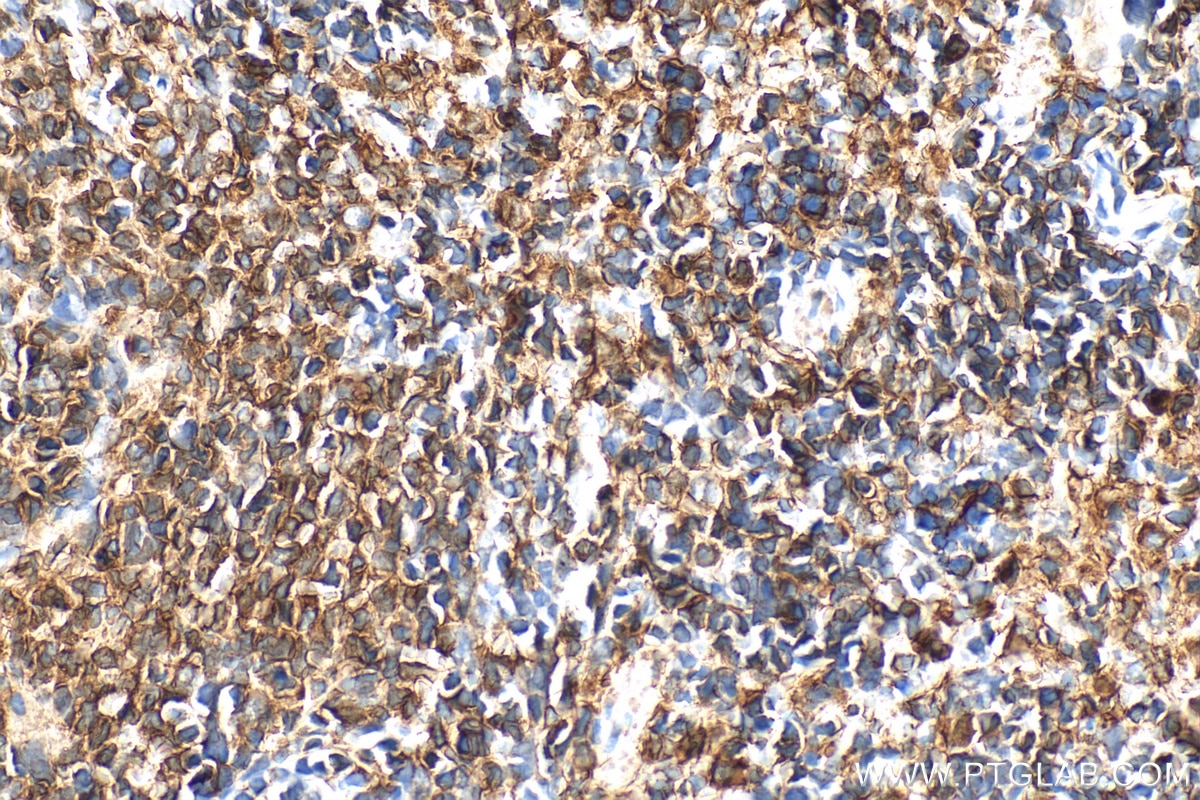
Immunohistochemical analysis of paraffin-embedded rat spleen tissue slide using 19013-1-AP (NOX2 antibody) at dilution of 1:1000 (under 40x lens). Heat mediated antigen retrieval with Tris-EDTA buffer (pH 9.0). Immunohistochemistry (IHC) staining of rat spleen tissue using NOX2 Polyclonal antibody (19013-1-AP)

Validation Data Gallery
Tested Applications
| Positive WB detected in | J774A.1 cells, human plasma, RAW 264.7 cells, mouse spleen tissue, rat spleen tissue |
| Positive IHC detected in | human tonsillitis tissue, mouse spleen tissue, rat spleen tissue Note: suggested antigen retrieval with TE buffer pH 9.0; (*) Alternatively, antigen retrieval may be performed with citrate buffer pH 6.0 |
| Positive IF-P detected in | mouse spleen tissue, human tonsillitis tissue |
| Positive IF-Fro detected in | mouse brain tissue |
| Positive FC (Intra) detected in | RAW 264.7 cells, MCF-7 cells |
Recommended dilution
| Application | Dilution |
|---|---|
| Western Blot (WB) | WB : 1:2000-1:10000 |
| Immunohistochemistry (IHC) | IHC : 1:500-1:2000 |
| Immunofluorescence (IF)-P | IF-P : 1:200-1:800 |
| Immunofluorescence (IF)-FRO | IF-FRO : 1:200-1:800 |
| Flow Cytometry (FC) (INTRA) | FC (INTRA) : 0.40 ug per 10^6 cells in a 100 µl suspension |
| It is recommended that this reagent should be titrated in each testing system to obtain optimal results. | |
| Sample-dependent, Check data in validation data gallery. | |
Published Applications
| KD/KO | See 6 publications below |
| WB | See 183 publications below |
| IHC | See 22 publications below |
| IF | See 26 publications below |
| CoIP | See 1 publications below |
Product Information
19013-1-AP targets NOX2 in WB, IHC, IF-P, IF-Fro, FC (Intra), CoIP, ELISA applications and shows reactivity with human, mouse, rat samples.
| Tested Reactivity | human, mouse, rat |
| Cited Reactivity | human, mouse, rat, pig, rabbit, canine |
| Host / Isotype | Rabbit / IgG |
| Class | Polyclonal |
| Type | Antibody |
| Immunogen |
CatNo: Ag5536 Product name: Recombinant human CYBB protein Source: e coli.-derived, PET28a Tag: 6*His Domain: 418-570 aa of BC032720 Sequence: SILKSVWYKYCNNATNLKLKKIYFYWLCRDTHAFEWFADLLQLLESQMQERNNAGFLSYNIYLTGWDESQANHFAVHHDEEKDVITGLKQKTLYGRPNWDNEFKTIASQHPNTRIGVFLCGPEALAETLSKQSISNSESGPRGVHFIFNKENF 相同性解析による交差性が予測される生物種 |
| Full Name | cytochrome b-245, beta polypeptide |
| Calculated molecular weight | 577 aa, 65 kDa |
| Observed molecular weight | 55 kDa |
| GenBank accession number | BC032720 |
| Gene Symbol | NOX2 |
| Gene ID (NCBI) | 1536 |
| RRID | AB_2833044 |
| Conjugate | Unconjugated |
| Form | |
| Form | Liquid |
| Purification Method | Antigen affinity purification |
| UNIPROT ID | P04839 |
| Storage Buffer | PBS with 0.02% sodium azide and 50% glycerol{{ptg:BufferTemp}}7.3 |
| Storage Conditions | Store at -20°C. Stable for one year after shipment. Aliquoting is unnecessary for -20oC storage. |
Background Information
NOX2, also named as CYBB, CGD, 91-phox, gp91-1, gp91-phox, p22 phagocyte B-cytochrome, cytochrome b-245 and beta polypeptide, is a critical component of the membrane-bound oxidase of phagocytes that generates superoxide. It is the terminal component of a respiratory chain that transfers single electrons from cytoplasmic NADPH across the plasma membrane to molecular oxygen on the exterior. This full length protein has three glycosylation sites. CYBB is found in human cardiomyocytes as multiple bands:the signal between 55 and 65 kDa is probably the unglycosylated protein, because the predicted molecular weight of unglycosylated CYBB protein is approximately 58 kDa(PMID: 17587483) to 65 kDa in phagocytes and the bands around 80 kDa probably represent glycosylated CYBB, as has also been shown in human umbilical vein endothelial cells(PMID:12610097). In other reports, it also can be detected a band of 91 kDa(PMID:19965781).
Protocols
| Product Specific Protocols | |
|---|---|
| FC protocol for NOX2 antibody 19013-1-AP | Download protocol |
| IF protocol for NOX2 antibody 19013-1-AP | Download protocol |
| IHC protocol for NOX2 antibody 19013-1-AP | Download protocol |
| WB protocol for NOX2 antibody 19013-1-AP | Download protocol |
| Standard Protocols | |
|---|---|
| Click here to view our Standard Protocols |
Publications
| Species | Application | Title |
|---|---|---|
Cell Host Microbe Zinc promotes microbial p-coumaric acid production that protects against cholestatic liver injury | ||
Circulation Megakaryocytic Leukemia 1 (MKL1) Bridges Epigenetic Activation of NADPH Oxidase in Macrophages to Cardiac Ischemia-Reperfusion Injury. | ||
Cell Host Microbe Gut microbiome dysbiosis contributes to abdominal aortic aneurysm by promoting neutrophil extracellular trap formation | ||
Brain Behav Immun Adiponectin ameliorates traumatic brain injury-induced ferroptosis through AMPK- ACC1 signaling pathway | ||
Sci Adv Sphingolipid biosynthesis is essential for metabolic rewiring during TH17 cell differentiation | ||
Redox Biol Silencing COX-2 blocks PDK1/TRAF4-induced AKT activation to inhibit fibrogenesis during skeletal muscle atrophy. |